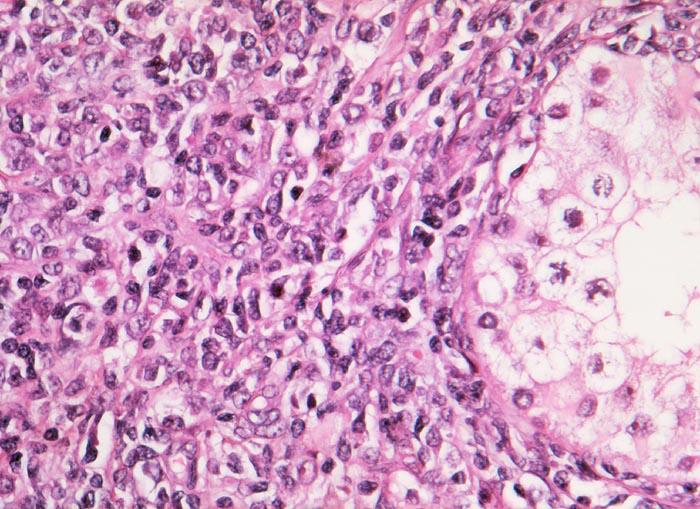

PathoPic – image database / PathoPic ID 3094 - Diffuses grosszelliges B-Zell Lymphom
de
Diagnose
Diffuses grosszelliges B-Zell Lymphom
Diagnose Gruppe
maligner Tumor
Topographie
Hoden
Topographie Gruppe
Genitalorgane, männlich
Beschreibung
Rechts im Bild der Anschnitt eines erhaltenen Hodentubulus. Im Interstitium ein diffuses Infiltrat von mittelgrossen bis grossen Lymphomzellen mit grossen blasigen Kernen und teilweise prominenten Nukleolen.
Zusatzbefund
Homogene beige Hodenschnittfläche.
Kommentar
Die Abgrenzung eines Seminoms oder embryonalen Karzinoms von einem hämatologischen Tumor kann schwierig sein, wenn man nicht daran denkt. Bei älteren Männern sind Keimzelltumoren abgesehen vom spermatozytischen Seminom sehr selten.
Bilder Typ
Histologie
Vergrösserung
320
Alter
72
Geschlecht
männlich
Datum
Ersteintrag: 21.03.2002
Update: 30.07.2010